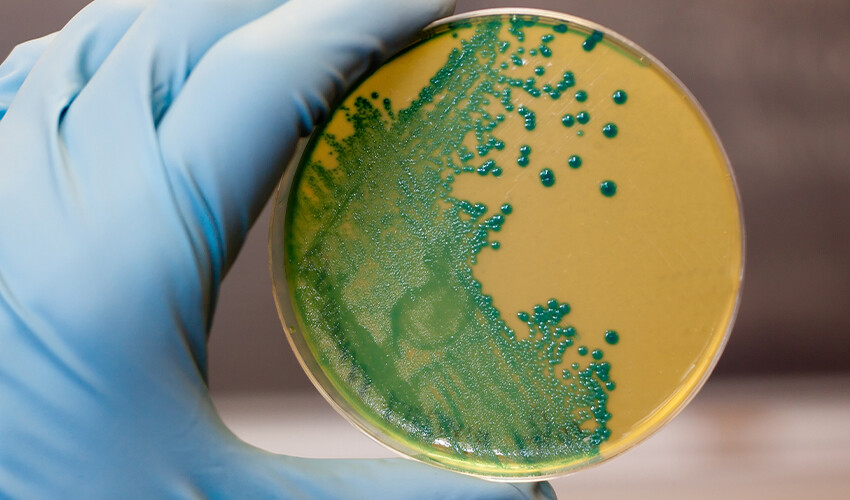
Yüksek ateş şikayetiyle hastaneye kaldırıldı, kalbinde ‘gizemli bakteri’ bulundu

Yüksek ateş şikayetiyle hastaneye kaldırıldı, kalbinde ‘gizemli bakteri’ bulundu

Bilim insanları Londra'daki bir hastanede daha önce hiç görülmemiş bir bakteri türü keşfetti. Yüksek ateşle hastaneye kaldırılan bir hastanın kanından örnek alan doktorlar, kalbinde gizemli bakteriye rastladı. Hastanın çobanlık yaparken üreme dönemindeki koyunlardan enfekte olduğu belirtildi.
İngiltere’de yüksek ateş şikayetiyle Thomas Hastanesi'ne kaldırılan 55 yaşındaki bir çobanın kanında iki farklı bakteri türü görüldü. Yapılan testlerde birinin türü belirlenirken, diğerinin daha önce hiç görülmediği tespit edildi.
FARKLI BİR TEKNOLOJİ KULLANDILAR
Araştırmacılar, gizemli bakteriye bir isim koymak için uzun ve tek DNA dizilerini diğer tekniklerden çok daha hızlı okuyabilen ‘nanopore sequencer’ adlı bir teknoloji kullandı.
Uluslararası Sistematik ve Evrimsel Mikrobiyoloji Dergisi'nde yayınlanan sonuçlar, toprakta yaygın olarak bulunan ve ‘Variovorax’ adı verilen bir bakteri grubunun daha önce hiç görülmemiş bir türünü gösterdi. Bu yeni tür, hastanın dolaşım sistemindeki en büyük atardamar olan aortunda keşfedildi.
KOYUNLARDAN KAPMIŞ OLABİLİR
St. Thomas Hastanesi’nde Uzman Registrar Lara Payne, hastanın gizemli mikrobu nasıl kapmış olabileceğini şöyle açıkladı:
“Hastanın kuzulama mevsiminde ya da koyunlara anti-parazit ilaçları verirken mikrobu kapmış olabileceğini düşündük. Bu işlem muhtemelen eldiven kullanılmadan yapıldı.”
Rapora göre bin 500 koyuna bakan çoban, kuzulama mevsiminde "çevresel patojenler için bir giriş noktası görevi gören ‘kronik dermatit (ciltte tahriş ve döküntü)’ geliştirdi.
ADINI KENDİ KOYDU
Hastanın isteği üzerine araştırmacılar yeni bakteriye hastanın memleketi Canterbury'nin Latince adı olan ‘Variovorax durovernensis’ adını verdi.
King's College London'da klinik araştırma görevlisi olan yazar Dr. Luke Blagdon Snell, bakteriyi keşfettikleri bu yeni teknolojinin kullanımı yaygınlaştıkça daha fazla bakteri keşfedeceklerinin altını çizdi. Ayrıca “Vücudumuzla etkileşime girip enfeksiyonlara neden oldukları yeni yolları ortaya çıkaracağız" öngörüsünde bulundu.
Araştırmanın yazarları yeni bakteri türlerinin kolayca tespit edilebilmesinin, hastaların daha hızlı ve daha hedefe yönelik tedaviler alabileceği anlamına geleceğini de sözlerine ekledi.


















